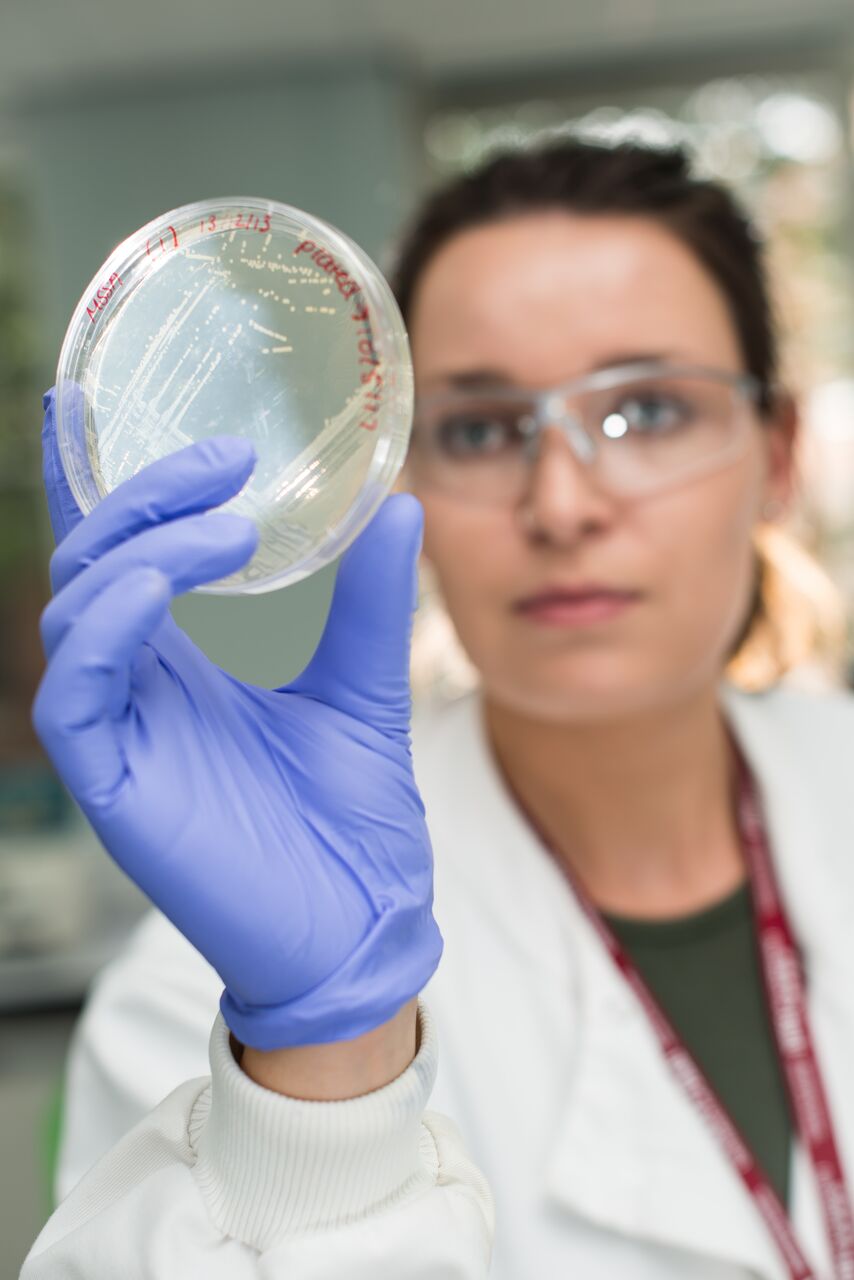
A student holding and looking through a petri dish

The climate emergency is one of the greatest threats facing human health. Our MSc in Health and Climate Change is for current and future health leaders who are prepared to meet that challenge head on.
You’ll study under academics with a broad range of specialisms from across the University and Hull York Medical School, developing the skills and expertise you need to become a leader in your chosen field of health and climate change.
Graduating with specialist knowledge, you’ll be equipped to research, design, and implement strategies and policies that address the impacts of climate change on public health.
Many of our MSc graduates have gone on to influential roles in the Environment Agency, UK Government, the NHS, local authorities, and charities, as well as sharing their expertise on international stages such as the UN High Level Political Forum.
Work on real-world research
and make a difference
Taught by experts
from across the University and Hull York Medical School
Recognised
for delivering CPD for a Greener NHS
Guest speakers
from organisations like WHO, YHCC & NHS
‘Think globally, act locally’
approach
About this course
You’ll study the current and predicted consequences of climate change on nutrition and health inequalities, illnesses, and infections and immunity. And explore strategies to lessen the impacts of climate change on public health, including sustainability of healthcare.
Taking a “think globally, act locally” stand, we teach you the impacts of environmental change on public health as well as local, place-based mitigation and adaptation strategies.
You will benefit from the expertise of academics across the University and Hull York Medical School who are at the forefront of public health and climate change research – enabling you to develop the skills and expertise you need to become a leader in your chosen field of health and climate change.
Our strong relationships within the sector and research-led teaching give you the chance to work on real-world case studies. You'll have the chance to hear from guest speakers from organisations such as the World Health Organisation (Prof. Dr. Emine Didem Evci Kiraz, an academician, climate and health expert with positions in WHO and UNDP), Yorkshire and Humber Climate Commission (YHCC), the National Health Service (NHS) and universities located in the Global South.
Your research skills will be enhanced carrying out a project in an area of your choice selected from a broad range of topics such as sustainability, decarbonisation or supply chain in response to climate change. You could also get the chance to carry out research with one of our partners for your project including East Riding of Yorkshire Council and ACA, the designers of the new, award-winning Allam Diabetes Centre in the hospital.
"All it takes is a willingness to see a change, climate change is changing the world that we know."
Victory Williams, MSc Health and Climate Change
View Victory’s video detailing her experience of joining the Health and Climate Change MSc at Hull.

MSc Health and Climate Change
2 mins
Module options
For a full Masters degree, you'll study 180 credits over the duration of your course. Some programmes offer a Postgraduate Diploma (PGDip) qualification or a Postgraduate Certificate (PGCert) qualification. For a PGDip, you'll study 120 credits, and for a PGCert, you'll study 60 credits.
No filters selected
Research Skills in Environmental Sciences
It is more important than ever that future environmental scientists are well-equipped with the skills needed to critically assess environmental research. This module will provide you with the key skills required to assess and integrate contemporary literature and to analyse and interpret complex data to become an independent researcher.
core
20 credits
Environmental Change in the Anthropocene
We are seeing unprecedented levels of change across the planet as a result of direct impacts due to human activity and resultant global changes. This has resulted in the designation of a new epoch – The Anthropocene. An understanding of the effects of these impacts and how humanity is responding (or not) to them is an essential component for the development of graduate environmental scientists. This module with its broad range of topics delivered by expert staff will illustrate how global change permeates every aspect of our existence.
core
20 credits
Environmental Change and Health 1
Learn about current and predicted impacts of climate change on health at the global scale, together with mitigation and adaptation strategies. Assessment will comprise of a written report and an oral presentation on a given health impact.
core
20 credits
Environmental Change and Health 2
Learn about current and predicted impacts of climate change on health at the global scale, together with mitigation and adaptation strategies. Assessment will comprise of a written report and an oral presentation on a given health impact.
core
20 credits
Infection and Immunity
Infections cause substantial disease, accounting for over a quarter of deaths around the world. Through this module, you will gain advanced knowledge of microbiology and immunology, exploring pathogen-host interactions, the immune response to infection, pathogenesis, and the mechanisms involved in protection against infection and vaccination. You will additionally gain understanding of how ageing populations, climate change, sprawling urbanization, migration, and ease of travel impact the infection burden and the emergence of new infectious diseases.
core
20 credits
Frontiers in Planetary Health
Gain critical reading and scientific thinking and writing skills and help you prepare for your dissertation project. You will select from a broad range of projects offered by academics in the Faculty of Health Sciences, and contribute your own ideas. Assessment will comprise of a project plan, in preparation for your dissertation
core
20 credits
Dissertation (Health and Climate Change)
Enhance your research skills by applying them to the investigation of a particular problem or issue within the broad area of health or the environment. You will select from a broad range of research topics offered by academics. Assessment will comprise of an original written piece of work and an oral presentation.
core
60 credits
Our academics
You'll benefit from the expertise of academics with a wide range of specialisms from across the University and Hull York Medical School, helping you appreciate the complex nature of the interactions between climate change and health.

Professor Lesley Smith
Professor of Women's Public Health
Lesley is widely published on alcohol research including alcohol and pregnancy and maternal health. She co-founded a social enterprise offering antenatal exercise and support in Oxford and has a nursing background.

Dr Pedro Beltran-Alvarez
Senior Lecturer in Health and Climate Change
Pedro researches health and biological responses to environmental changes. His research in this area has been funded by the British Heart Foundation, NERC, Yorkshire Brain Tumour Charity and Hull and East Riding Cardiac Trust Fund.
Entry Requirements
What do I need?
When it comes to applying for this Postgraduate Taught degree, you'll need an Undergraduate degree (or equivalent). For this course, you'll need a 2:2 from a relevant bachelor's degree.
The programme is designed for graduates who have studied a subject that is relevant to this course.
If you’re an undergraduate student at Hull, you’re guaranteed a fast-track route to this postgraduate degree, as long as you meet the entry requirements.
In order to ensure our students have a rich learning and student experience, most of our programmes have a mix of domestic and international students. We reserve the right to close applications early to either group if application volumes suggest that this blend cannot be achieved.
Typical offer
2:2 in a relevant subject area
Applicants should have a minimum of a 2:2 Honours degree or international equivalent in a programme related to health sciences, for example: health sciences, medicine, public health, biomedical science and biomedical sciences.
Fees & Funding
How much is it?
Scholarships
We offer a number of awards, bursaries and scholarships for eligible students. They’re awarded for a variety of reasons including academic achievement and/or to help those on lower incomes.
Scholarships and bursaries are separate to student loans. And the best bit is, you don’t pay a penny back.
Alumni Postgraduate Scholarship
University of Hull undergraduates progressing to a taught masters course may receive a 20% discount on the cost of their tuition fees.
Find out if you’re eligible by visiting the University of Hull Alumni Postgraduate Scholarship page.
See more Scholarships
We offer a range of scholarships and awards to students at the university to help with their financial load.
To view all of our scholarships and determine whether you're eligible, please visit our Scholarships and Awards page.
Our facilities


Future prospects
Previous students of this MSc have gone on to work for the UK Government, the NHS, the Environment Agency, local authorities, charities, and made impact through delivering talks to the UN High Level Political Forum.
You'll graduate with the specialist knowledge you need for a range of professions in environment and human health or to progress to a PhD in the field.
You could go on to work in a variety of sectors including local and regional authorities and organisations, contributing to mitigation and adaptation policies. Or within the private sector, working for businesses that need to comply with environmental and health policies and regulations. As well as national organisations with a remit of environment and health such as the Environment Agency, Greener NHS, UKHSA, and charities such as The Wellcome Trust.
You could also go on to roles within international organisations that lead on public health and climate change response, such as the UN and the WHO. Previous students of this MSc have gone on to work for the UK Government, the NHS, local authorities, charities, and made impact through delivering talks to the UN High Level Political Forum.
Take a look at MSc student Victory Williams sharing her experience of studying Health and Climate Change at the University of Hull here.
Take your career to the next level
Like what you’ve seen? Then it’s time to apply.
Make your application online now, and our admissions team will get back to you as soon as possible to make you an offer.
Not ready to apply yet?
We regularly deliver virtual and on-campus events to help you discover your perfect postgraduate course, whether it’s a subject you already love or something completely different. Our events are an opportunity for you to chat to tutors and current students and find out about the career options a postgraduate degree could lead to.
You may also be interested in...
MSc Health Research
Postgraduate Taught
Advance healthcare with research skills that drive real change and shape the future. Apply now.
MSc Environmental Change, Management and Monitoring
Postgraduate Taught
Gain an in-depth understanding of the causes and impacts of environmental change, and the skills and tools to monitor and manage them.
MSc Biomedical Sciences
Postgraduate Taught
The MSc in Biomedical Sciences teaches students to understand the importance of research and experience advanced research techniques.
All modules on this course page are subject to availability and this list may change at any time.